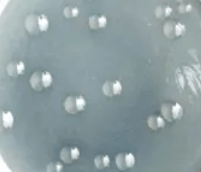

Silicate bacteria mainly refer to a variant of Bacillus mucilaginosus or B. circulans, and other identified strains.
On the one hand, due to the organic acids produced by their growth and metabolism, silicate bacteria can dissolve insoluble potassium and phosphorus from potassium-containing minerals such as feldspar, mica, apatite, and phosphate rock powder in the soil for crops and bacteria. The body itself utilizes it, and the potassium rich in the bacteria is absorbed by the crops after the bacteria die; on the other hand, the hormones, amino acids, polysaccharides and other substances it produces promote the growth of crops. At the same time, bacteria multiply in the soil and inhibit the growth of other pathogenic bacteria. These have a good effect on crop growth, yield increase and quality improvement.
Content : 1-10 billion /g